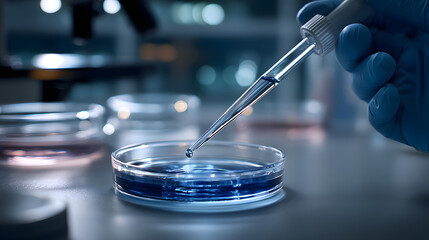
Obraz premium Investigación científica con pipeta dosificando líquido en placa de Petri en laboratorio moderno

RABAT DO 40% - wygasa 11.12 !!! | Darmowa dostawa od 290zł | Potrzebujesz pomocy? Zadzwoń 22 678 07 67
(0)
Produkt dodany poprawnie do Twojego koszyka
Ilość
Razem
Ilość produktów w Twoim koszyku: 0. Jest 1 produkt w Twoim koszyku.
Razem produkty:
Dostawa: Do ustalenia
Razem
Kontynuuj zakupy Przejdź do realizacji zamówienia
Jakiego obrazu szukasz?
Użyj wyszukiwarki i szukaj wśród milionów zdjęć.
Obrazy Wyniki wyszukiwania "precyzja"
- #1600923532
- #1795075803
- #1665748800
- #1549959503
- #1700734196
- #1736656446
- #1828309550
- #1594946468
- #1592504062
- #1646753123
- #1665748794
- #1772964255